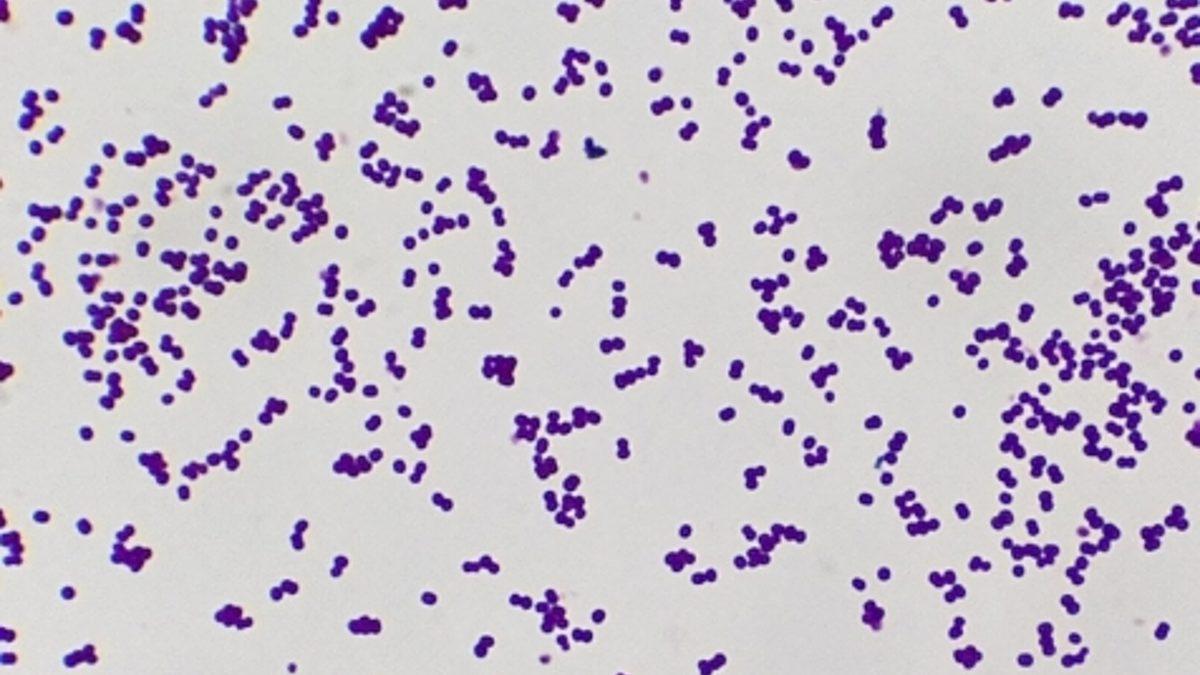
Kanser Tedavilerinde Devrim Yaratabilecek Araştırma: İnsan Vücudunda da Bulunan Bir Bakteri Yoluyla Tümör Yok Edildi!

Kanser tedavisine yönelik çalışmalar hız kesmeden devam ederken geçtiğimiz günlerde bu konuda oldukça önemli bir gelişme yaşandı. ABD’de bulunan Stanford Medicine’dan araştırmacılar, kanser tedavilerinde devrim yaratabilecek bir keşifte bulundular.
Bilim insanları, bunun için ciltte bulunan bazı bakterilerden yararlandılar. Kanserle savaşabilmek ve tedaviyi üretmek için de bu organizmaların genomları değiştirildi.
Tedavinin fareler üzerinde başarılı olduğu görüldü
Yapılan testlerde bu değiştirilmiş bakteri, kanserli farelere verildi. Bunun sonucunda da tümörlerin yok olmaya başladığı gözlemlendi. Buradaki bahsedilen şey, “Staphylococcus epidermidis” isimli farelerin tüylerinden alınan bir bakteri. Bu bakteri, bağışıklık sistemini uyaran bir protein üretmek için değiştirildi.
Araştırmacılardan Michael Fischbach da yaptığı açıklamalarda sonuçları “sihir gibi*”* olarak nitelendirdi. Fischbach, farelerin oldukça agresif tümörlere sahip olduğunu söylerken tedavinin kolaylığına da dikkat çekti. Buna göre tedavi, farelerden bakteri alınıp değiştirildikten sonra kafalarındaki tüylere sürülmesiyle gerçekleşti.
Bilim insanları, bu bakterinin bağışıklık hücreleri olan CD8 T hücrelerinin üretimini tetiklediğini buldular. Araştırmalarında da temel olarak bu bakteri yoluyla spesifik antijenleri hedefleyen CD8 T hücrelerini ürettiler. Buradaki durumda bu antijenler cilt kanserine yönelikti. Hücreler tümörle karşılaştığında başarılı sonuç ortaya çıktı. Bu hücreler, hızla çoğalarak kütleyi küçültmeyi veya tümörü tamamen ortadan kaldırmayı başardı.
Birkaç yıl içinde insanlı deneyler başlayabilir

Fiscbach da açıklamalarında, “Bu tümörlerin, özellikle de bakterileri uyguladığımız yerden uzak bir bölgede, yok olduğunu izlemek şok ediciydi” dedi. Tabii ki henüz kesin bir şey söylemek mümkün değil. İnsanlarda sıkça görülseler de, Staphylococcus epidermidis bakterisinin farelerde olduğu gibi bizde de bağışıklık tepkisini tetikleyip tetiklemeyeceğini bilemiyoruz. Ancak, farklı bir bakterinin kullanılabileceğini; bu yüzden araştırmanın umut verici olduğunu söyleyebiliriz.
Araştırmacılar, tedavi konusunda daha fazla araştırmaya ihtiyaç olduğunu söylese de birkaç yıl içinde insanlı deneylerin başlamasını beklediklerini söylüyor. Ayrıca, tedavinin kanser hücrelerinin dışında her türlü bulaşıcı hastalığa karşı kullanılabilme ihtimali olduğu da söyleniyor.
